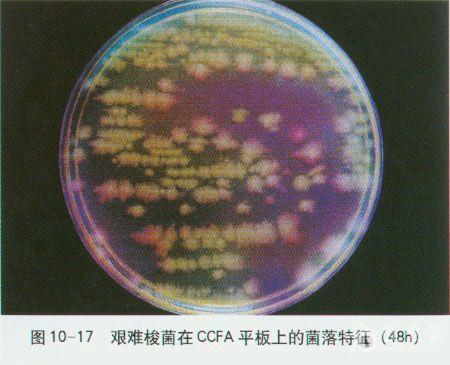
微生物图谱之厌氧菌

无芽胞厌氧菌

无芽胞厌氧菌
图片尺寸300x268
无芽胞厌氧菌
图片尺寸268x202
厌氧菌简介
图片尺寸579x401
厌氧菌
图片尺寸275x183
在电子显微镜下的厌氧菌照片
图片尺寸450x300
很少数是放线菌,极少数是支原体,厌氧真菌尚见于个别的报道
图片尺寸443x401
p>厌氧菌(anaerobic bacteria)也叫厌气菌.
图片尺寸811x528
微生物图谱之厌氧菌
图片尺寸446x360
厌氧菌竟会导致口腔感染?口腔护理不可少!
图片尺寸640x481
生物厌氧
图片尺寸500x400
微生物图谱之厌氧菌
图片尺寸450x365
无芽胞厌氧菌(anaerobic bacteria) 包括一大类常存于肠腔,前尿道,口
图片尺寸1080x810
产酸产气,需氧和兼性厌氧的革兰氏阴性无芽胞杆菌
图片尺寸414x403
生物厌氧
图片尺寸1037x768
延禧攻略高贵妃究竟死于哪种细菌感染
图片尺寸656x440
无芽胞厌氧菌
图片尺寸136x94
2,无芽孢厌氧菌,革兰阳性的球菌和杆菌.
图片尺寸640x480
厌氧微生物
图片尺寸1120x840
培养48小时后细小针尖菌落,革兰阳性无芽胞厌氧杆菌.
图片尺寸885x860
梭状芽孢杆菌
图片尺寸1080x810